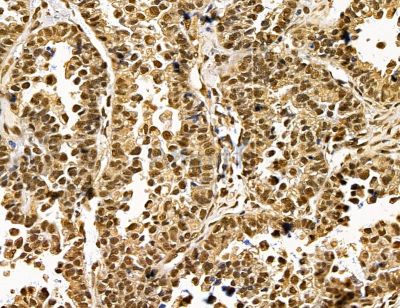
DDX39B Antibody - DF14568 at 1/100 staining human ovarian cancer by IHC-P.

DDX39B Antibody - #DF14568
Related Downloads
Protocols
Product Info
*The optimal dilutions should be determined by the end user. For optimal experimental results, antibody reuse is not recommended.
*Tips:
WB: For western blot detection of denatured protein samples. IHC: For immunohistochemical detection of paraffin sections (IHC-p) or frozen sections (IHC-f) of tissue samples. IF/ICC: For immunofluorescence detection of cell samples. ELISA(peptide): For ELISA detection of antigenic peptide.
Fold/Unfold
0610030D10Rik; 4F2-LC6; 56 kDa U2AF65-associated protein; AI428441; ATP-dependent RNA helicase p47; B(0,+)-type amino acid transporter 1; BAT1; Bat1a; D17H6S81E; D17H6S81E-1; D6S81E; D6S81Eh; DDX39B; DEAD (Asp-Glu-Ala-Asp) box polypeptide 39B; DEAD box protein UAP56; DX39B_HUMAN; EC 3.6.1.-; Glycoprotein-associated amino acid transporter b0,+AT1; HLA-B-associated transcript 1 protein; HLA-B-associated transcript 1A; HLA-B-associated transcript-1; MGC127051; MGC19235; MGC38799; nuclear RNA helicase (DEAD family); OTTHUMP00000029229; OTTHUMP00000165889; OTTHUMP00000165890; p47; Solute carrier family 7 member 9; Spliceosome RNA helicase BAT1; Spliceosome RNA helicase DDX39B; U2AF65-associayed protein, 56-KD; UAP56;
Immunogens
A synthesized peptide derived from human DDX39B.
- Q13838 DX39B_HUMAN:
- Protein BLAST With
- NCBI/
- ExPASy/
- Uniprot
MAENDVDNELLDYEDDEVETAAGGDGAEAPAKKDVKGSYVSIHSSGFRDFLLKPELLRAIVDCGFEHPSEVQHECIPQAILGMDVLCQAKSGMGKTAVFVLATLQQLEPVTGQVSVLVMCHTRELAFQISKEYERFSKYMPNVKVAVFFGGLSIKKDEEVLKKNCPHIVVGTPGRILALARNKSLNLKHIKHFILDECDKMLEQLDMRRDVQEIFRMTPHEKQVMMFSATLSKEIRPVCRKFMQDPMEIFVDDETKLTLHGLQQYYVKLKDNEKNRKLFDLLDVLEFNQVVIFVKSVQRCIALAQLLVEQNFPAIAIHRGMPQEERLSRYQQFKDFQRRILVATNLFGRGMDIERVNIAFNYDMPEDSDTYLHRVARAGRFGTKGLAITFVSDENDAKILNDVQDRFEVNISELPDEIDISSYIEQTR
Research Backgrounds
Involved in nuclear export of spliced and unspliced mRNA. Assembling component of the TREX complex which is thought to couple mRNA transcription, processing and nuclear export, and specifically associates with spliced mRNA and not with unspliced pre-mRNA. TREX is recruited to spliced mRNAs by a transcription-independent mechanism, binds to mRNA upstream of the exon-junction complex (EJC) and is recruited in a splicing- and cap-dependent manner to a region near the 5' end of the mRNA where it functions in mRNA export to the cytoplasm via the TAP/NFX1 pathway. May undergo several rounds of ATP hydrolysis during assembly of TREX to drive subsequent loading of components such as ALYREF/THOC and CHTOP onto mRNA. The TREX complex is essential for the export of Kaposi's sarcoma-associated herpesvirus (KSHV) intronless mRNAs and infectious virus production. Also associates with pre-mRNA independent of ALYREF/THOC4 and the THO complex. Involved in the nuclear export of intronless mRNA; the ATP-bound form is proposed to recruit export adapter ALYREF/THOC4 to intronless mRNA; its ATPase activity is cooperatively stimulated by RNA and ALYREF/THOC4 and ATP hydrolysis is thought to trigger the dissociation from RNA to allow the association of ALYREF/THOC4 and the NXF1-NXT1 heterodimer. Involved in transcription elongation and genome stability.
Splice factor that is required for the first ATP-dependent step in spliceosome assembly and for the interaction of U2 snRNP with the branchpoint. Has both RNA-stimulated ATP binding/hydrolysis activity and ATP-dependent RNA unwinding activity. Even with the stimulation of RNA, the ATPase activity is weak. Can only hydrolyze ATP but not other NTPs. The RNA stimulation of ATPase activity does not have a strong preference for the sequence and length of the RNA. However, ssRNA stimulates the ATPase activity much more strongly than dsRNA. Can unwind 5' or 3' overhangs or blunt end RNA duplexes in vitro. The ATPase and helicase activities are not influenced by U2AF2; the effect of ALYREF/THOC4 is reported conflictingly with [] reporting a stimulatory effect.
Nucleus. Nucleus speckle. Cytoplasm.
Note: Can translocate to the cytoplasm in the presence of MX1. TREX complex assembly seems to occur in regions surrounding nuclear speckles known as perispeckles.
The helicase C-terminal domain mediates interaction with ALYREF/THOC4.
Belongs to the DEAD box helicase family. DECD subfamily.
Research Fields
· Genetic Information Processing > Translation > RNA transport.
· Genetic Information Processing > Translation > mRNA surveillance pathway.
· Genetic Information Processing > Transcription > Spliceosome.
· Human Diseases > Infectious diseases: Viral > Influenza A.
Restrictive clause
Affinity Biosciences tests all products strictly. Citations are provided as a resource for additional applications that have not been validated by Affinity Biosciences. Please choose the appropriate format for each application and consult Materials and Methods sections for additional details about the use of any product in these publications.
For Research Use Only.
Not for use in diagnostic or therapeutic procedures. Not for resale. Not for distribution without written consent. Affinity Biosciences will not be held responsible for patent infringement or other violations that may occur with the use of our products. Affinity Biosciences, Affinity Biosciences Logo and all other trademarks are the property of Affinity Biosciences LTD.